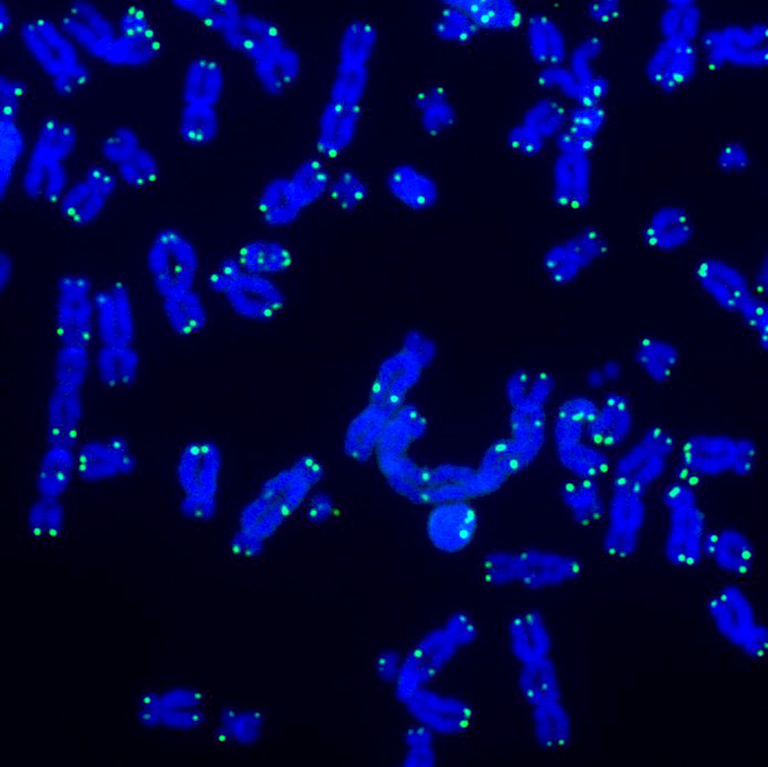

image: A microscope image showing telomeres (green), the protective caps at the ends of chromosomes (blue), that play an important role in cellular aging. credit: Salk Institute
Salk Institute scientists have unveiled a new method to determine both the length and sequence of telomeres on individual chromosomes. Their groundbreaking anti-aging and cancer telomere technology research Nature Communications New insights into telomere dynamics in health and disease have been uncovered. This innovation lays the foundation for tracking telomere dynamics during aging and disease, leading to new discoveries that could transform health and longevity.
What are telomeres?
Long strands of DNA are folded into chromosomes within each cell, and telomeres, the protective end caps that help store all of this important information in chromosomes. But as we age, telomeres shorten and eventually thin out, exposing chromosomes and causing the cell to die. The details of how and when this happens, or whether certain chromosomes are more susceptible than others, are hot topics in the fields of anti-aging, regenerative medicine, and longevity.
A revolution in telomere sequence analysis
Recently, the Salk Institute, working closely with experts at Oxford Nanopore Technologies, developed a groundbreaking tool, Telo-seq, that is designed to revolutionize telomere science, the study of telomeres in ageing and disease. Current methods struggle to sequence entire telomeres and can only measure their average length across all chromosomes. This method allows researchers to determine the entire sequence and exact length of each telomere on each chromosome.
“Previous methods for measuring telomere length have been low-resolution and highly inaccurate,” say the study’s lead author. Jan Karlseder“We’ve been able to hypothesize about what role individual telomeres play in aging and cancer, but it’s never been possible to test those hypotheses. Now we can,” said Dr. Darren Shiley, professor, chief scientific officer and Donald Professor of Aging Research at the Salk Institute.
Telomere Science
The collaboration combines aspects of long-read sequencing technology with novel biochemical and bioinformatics approaches, and the resulting method starts at the end of each telomere and sequences down to the subtelomeric regions, allowing scientists to pinpoint which chromosome they are looking at and examine the structure and composition of its telomeres in unprecedented detail.
What they have observed so far
This new method has accounted for numerous features of telomere biology that were previously inaccessible to scientists: for example, within an individual human sample, the telomeres on each chromosome arm can vary in length, and the rate at which these telomeres shorten can also vary substantially.
These dynamics can vary across tissues and cell types within the same individual, which could be due to a number of reasons, including the amount of stress and inflammation affecting different parts of the body. Taken together, these findings suggest that there may be chromosome arm specific factors that influence telomere dynamics in aging and disease.
“Aging is a very diverse process that affects different people differently,” says Karlseder, “and we’re very interested in whether differences in aging are related to differences in the rate at which telomeres shorten across people and chromosomes, and how we can slow this down and promote healthy aging.”
Telomere shortening
Many telomeropathies involve stem cells whose telomeres no longer have the same length, causing the cells to lose their ability to divide into new cells. When this happens, it can lead to certain cancers, hair loss and immune disorders. This telomere technology will allow researchers to investigate whether these diseases are hereditary or linked to individual chromosomes and develop targeted interventions.
Overactivation of repair mechanisms
Shortening telomeres affects the lifespan of cells, but overworking the repair mechanisms can be just as damaging: When this happens, cells become immortal and can divide indefinitely, potentially causing cancer.
Cells can repair damaged telomeres using the enzyme telomerase or the alternative telomere lengthening machinery (ALT). However, telomere length and composition vary depending on the machinery used. Until now, researchers have had no efficient way to measure this.
“With Telo-seq, we can quickly determine whether a cancer is telomerase-positive or ALT-positive,” says lead author Tobias Schmidt, a postdoctoral researcher in the Karl Seder lab. “This is crucial, as ALT-positive cancers are more aggressive than telomerase-positive cancers and often require a different therapeutic approach. In this sense, Telo-seq can be used as a fast and reliable diagnostic tool to identify the type of cancer and guide more personalized treatment plans.”
Just the tip of the iceberg
Beyond its immediate clinical applications, the researchers believe the biggest impact of this telomere technology will be that it will inspire new fields of more precise telomere research. The possibilities unlocked by this revolutionary technology are far-reaching, from discovering missing puzzle pieces to fundamental mechanisms of aging and developing treatments for telomere-related cancers and diseases.
“Telosequencing will enable us to answer questions about development, aging, stem cells and cancer that we couldn’t answer with previous tools,” Karlsleder says. “We don’t even know what we’ve been missing until now. I think what we know now is just the tip of the iceberg. It’s a very exciting time for telomere science.”